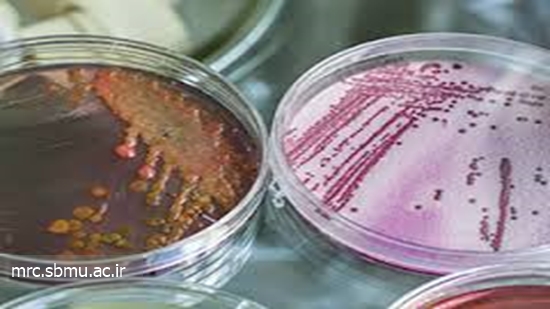

بهینه سازی غربالگری عفونت سلی نهفته در بیماران مبتلا به آرتریت روماتوئید
بیماران مبتلا به آرتریت روماتوئید ( RA ) در معرض خطر فزاینده ابتلا به عفونت سلی نهفته می باشند اما دستورالعمل واضح و روشنی برای غربالگری با استفاده از تست پوستی توبرکولین ( TST ) و تست طلایی کوانتی فرون سل (QTB-G ) وجود ندارد. بنابراین؛ مطالعه گذشته نگری برای بررسی بیمارن مبتلا به RA که هر دو تست TSTو QTB-G را داشته اند انجام گرفت
بیماران مبتلا به آرتریت روماتوئید ( RA) در معرض خطر فزاینده ابتلا به عفونت سلی نهفته می باشند اما دستورالعمل واضح و روشنی برای غربالگری با استفاده از تست پوستی توبرکولین ( TST) و تست طلایی کوانتی فرون سل (QTB-G ) وجود ندارد. بنابراین؛ مطالعه گذشته نگری برای بررسی بیمارن مبتلا به RAکه هر دو تستTSTو QTB-G را داشته اند انجام گرفت. با آنالیز داده ها آشکار گردید که همخوانی کمی میان دو تست TSTو QTB-Gوجود دارد. در غیاب یک پروتکل تعریف شده استاندارد و ومحدودیت های مرتبط با هر دو تست، محققان برای بیمارانی که نیازمند درمان فوری با تعدیل کننده های پاسخ بیولوژیکی BRMs)) می باشند؛ غربالگری زودهنگام با هردو تست TSTو QTB-Gرا پیشنهاد می نمایند. بیمارانی که کاندیدای درمان فوری نمی باشند در یک پروسه دو مرحله ایی به طور ایمن و مقرون به صرفه غربالگری می گردند: غربالگری اولیه با TSTو چنانچه منفی باشند از تست انتشار اینترفرون گاما ( IGRA) استفاده می گردد. همچنین ضروری است بیمارانی که نتیجه آزمایش آنان با استفاده از هرکدام از این دوتست مثبت اعلام گردیده سریعا درمان شوند.
منبع : www.ncbi.nlm.nih.gov


نظر